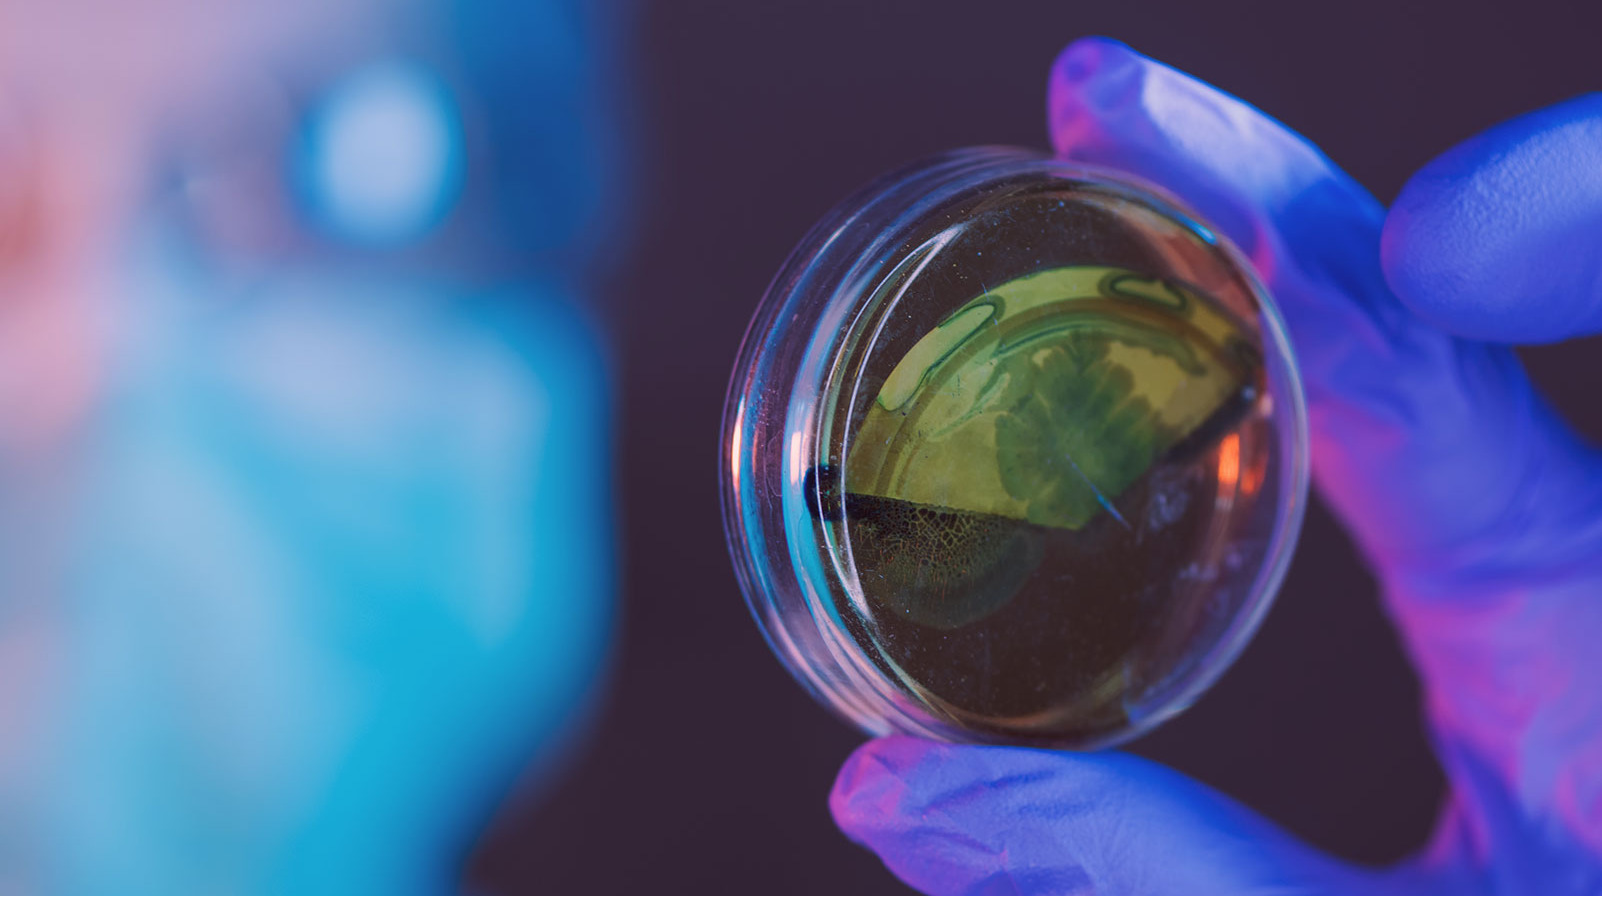

Probionova SA
Exhibitors
Information
We are a young company specializing in human microbiome research and development, with a focus on preventive medicine and precision probiotic supplementation.
Our goal is to offer innovative, science-based solutions that enable you to live your best life every day. We have proprietary probiotic strains and unique combos of multiple strains designed to provide benefits beyond the gut.
We create the probiotic supplement of tomorrow.
Business Sector
Ingredients & Raw Materials
Country
Italy
Category
- Finished Products
- Specialised Finished Food Products
- Biotic products
- Dietary supplements
- Ingredients
- Microorganisms & Probiotics

